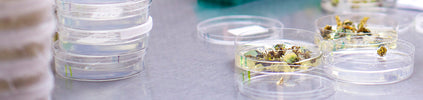
18 Questions About Getting Published During Grad School

18 Questions About Getting Published During Grad School
by Rebecca Talley
by Rebecca Talley
Whether you’re already in graduate school or you’re an undergrad who will be joining a Ph.D. program soon, you probably have questions about publishing papers. One common saying in grad school is “publish or perish” but is that true? What all do you need to know to get your paper published while you are still a student? I have answered 18 of the most popular questions graduate students have about getting published.
When can you say you’re really published? Is it only after your work shows up in a journal? What about your thesis—does the work you did for your senior thesis or poster project mean you’re published?
The answer is simple: Being published means your work was published in a peer-reviewed journal and you’re among the first two authors of the paper (certainly there are exceptions to that rule).
|
|
||
You generally won’t be considered “published” unless you’re one of the first two authors on the paper. Therefore, coauthoring definitely counts as long as you were one of the first two authors listed. This also means that acknowledgements don’t count. Acknowledgements are usually used for people who had minor contributions to the research being published.
|
|
||
In most cases—yes. With few exceptions, all scientific journals—open access and otherwise—are peer-reviewed. While most are peer-reviewed prior to being published, some journals use post-publication peer review. In this case, the paper may or may not have undergone peer-review prior to being published, but will be reviewed by invited reviewers or volunteer reviewers. The reviewed paper should be marked as peer-reviewed after this occurs. However, there are some open-access journals that claim to be peer-reviewed but don’t show evidence of it actually occurring. They are commonly called predatory journals and you want to be careful not to publish in a journal like this since it has little to no credibility once the scientific community begins to realize there is not actually a referee process in place.
|
|
||
When you should start publishing scientific papers really depends both on your experience and what field you are in. The obvious answer is to start publishing as soon as you have something to publish. You definitely don’t want to wait to publish something novel because it is possible that someone else could get to it before you. At the same time, you don’t want to publish too early and have a paper of lesser quality in a less respected journal. There is a sweet-spot somewhere in between that you and your mentor can work together to find.
Some students have their first papers published during undergrad, while others wait until graduate school. There is even variance among the year of your Ph.D. education in which you publish—some will be able to get their name on a paper during their first year, while others won’t publish until a few years down the road. It is important to note that quality is more important than quantity so take your time to produce your best work rather than rushing to get your name on the most papers.
|
|
||
The first step to getting published is starting a project and getting results, which makes sense because without it, you’d have nothing to write about. Once you have results, you will need to analyze them and determine their significance in your field. If they are significant, you have something to publish! Now it’s time to work with your team to decide who will have which roles in the writing process and who will be authors of the paper so that this is not an issue down the line. The next step is to get all of your charts and graphics ready—often times these are the first or only parts of a paper a person looks over so they can be used to guide your writing. Develop your first draft and then create an abstract for your paper. Edit your paper and have others give you feedback. Once your paper is ready, you will want to adjust the formatting to fit the journal’s requirements before submitting.
|
|
||
A lot of what publishers are looking for will depend on the publisher, the field and who makes up a majority of their readers. Almost every journal has an online page with instructions for authors. This page will contain all of the necessary information you need to cater your paper to the particular journal you wish to submit it to. Not following these guidelines would be an easy way for your paper to be rejected without even being considered, so make sure to make adjustments for each journal to which you apply.
|
|
||
Generally, the answer is no. Most peer-reviewed journals have terms and conditions which require that your paper is not being simultaneously submitted to another journal. This is done to respect the time and effort reviewers and editors put into accepting papers, and ensures that you will not rescind your submission after they have started looking at it. You should submit to your first choice journal first and then if it is not accepted, move to your second choice and so on. By doing so, you will not come to the difficult decision of deciding whether you should publish in one journal or wait to see if another journal will accept your work. Your first choice option will always come first. With that beings said, you should be reasonable about what journals may accept your paper or you will waste a lot of valuable time. Dream big, but stay reasonable.
|
|
||
In theory, students are able to publish in any journal. However, it’s pretty rare for undergraduates to get published at all in highly recognized journals, especially in the first author position.
A lot of getting published as a student has to do with knowing where to submit your work. Try to submit to journals that publish research similar to yours because this will give you the best chance of getting published.
You can look into publishing in second-tier journals as well. These journals are the ones that are less well-known in the field, but are still peer-reviewed and publish quality work. Some students even start by publishing in journals that focus on student research. Look for student-run journals that are dedicated to publishing work of young scientists. Your university may even have a publication of its own that you can submit your work to.
|
|
||
After you’ve submitted your paper, it’s time to play the waiting game. It can take months for reviewers to get to your manuscript, so in the meantime, you can begin to prepare to submit to another journal or get started on another project. Just remember, you usually can’t submit to another journal, unless your proposal is not accepted at the place you are waiting to hear back from. If your article is accepted for review, you will get feedback on your paper. You will then need to make revisions and resubmit the paper. If your paper is accepted for publication, you can make final edits before it is published.
|
|
||
The cost of publishing varies depending on the journal you will be publishing in. Some journals have no cost at all, while others can cost up to $3,500. Other journals charge you per page, so the length of your publication can determine the cost. They may charge around $50 per page plus around $300 per color image. There may also be submission fees associated with publishing. While this seems very costly, the good news is your PI will generally take care of publishing costs.
|
|
||
If you’re an undergrad, the answer is no. However, if you’re a grad student, the answer to this question depends on your institution’s graduation requirements. Some schools require at least one publication before you can graduate, but others have no requirement about this at all. The best thing you can do is become familiar with your institution’s requirements about publishing early on in your time there. If you are aware of all requirements, you can begin to work towards a publication from the beginning and have a plan to get your research published as soon as possible.
Regardless of whether or not there is a publishing requirement, you should make publishing during graduate school one of your top priorities. This will help open doors for your future career as a professional scientist.
|
|
||
This will depend on what type of job you plan to apply for. If you want to go into academia, the answer is no. You will need to start a postdoctoral fellowship and publish during this time. You may even need to complete more than one postdoc to become competitive with others who will be applying for academic positions.
However, if you are looking to get a job outside of academia, having a publication in your name is a lot less important. Most industry positions do not require you to have a publishing background and this holds true for other jobs. Check out my previous article on alternative careers for life scientists if you are looking to pursue a career outside of the academic world.
|
|
||
Technically speaking, your thesis will be published by your institution. However, this does not count as an official publication. Nevertheless, the best thing a life sciences graduate student can do is publish throughout his or her time as a graduate student. Once you have a few publications and are ready to work on your thesis, you can obtain permission from the journals you published in to compile all of your manuscripts into one document to serve as your thesis.
|
|
||
A journal’s impact factor is an average of the number of citations the journal receives in the previous year. It has been used to gauge how important a journal is in a certain scientific field, with higher impact scores being associated with more important journals. This can help you to gauge which journals you want to submit to first and which journals may be second-tier that you can try to submit to if your work is not accepted by journals of a higher impact factor. Remember that impact factor is not everything, however. Some journals even artificially elevate their own impact score by publishing a large percentage of review articles that are likely to be cited more often than primary research.
|
|
||
The number of papers you should aim to publish will depend on the field you are working in. For most life science fields, a good number to shoot for publishing during your Ph.D. program is two papers. Talk to your peers and advisors and find out what is typical of students at your institution and in your department. This will give you a good idea of what is expected of you.
If you’re an undergrad, getting your name on a single paper is a big accomplishment, especially if you go to a small school where less professors are working on research projects.
|
|
||
The most common mistake that we found through crowdsourcing is graduate students putting off writing their manuscripts until it is time for their dissertation. Instead of having published a little at a time along the way, which looks better on your CV, some people try to do it all at once and become overwhelmed. Work on writing throughout your time as a grad student.
|
|
||
One of the biggest challenges you will face as a graduate student trying to publish is inexperience writing a manuscript. This type of writing is different than papers you have written in the past. The best things you can do are read literature from your field to get a feel for how it is written and spend time writing. Learning takes time and the best way you can learn is to start doing writing early on. Your writing will improve immensely by the time your write your thesis for graduation.
|
|
||
If you’re still an undergrad, don’t worry. Getting published now is not essential. However, if you are on a research team and have a project that you are interested in publishing, talk to your advisor about his or her recommendations. Where you submit your work will greatly depend on the quality and novelty of your project.
![]() Rebecca Talley GoldBio Staff Writer |
Rebecca is a medical student at the University of Missouri. She previously worked as a lab technician while studying biology at Truman State University. As an aspiring reproductive endocrinologist with an interest in global health, Rebecca has traveled across Central America on medical mission trips. With a passion for the life sciences, she enjoys writing for GoldBio. |
Category Code: 79104, 79108
The GoldBio Floating Tube Rack is one of our more clever giveaways because of the unique purpose it serves. And, with it also being one...
The characteristic blue color of nickel agarose beads comes from the 2+ oxidation state of the nickel ions. Color is also a useful indicator for...
GelRed™ and GelGreen™ are both DNA gel stains designed as safer alternatives to ethidium bromide, with no detectable mutagenicity at concentrations used for DNA gel...
Nickel agarose beads are compatible with a wide range of buffers. However, it is important to limit the amount of metal chelating agents, such as...